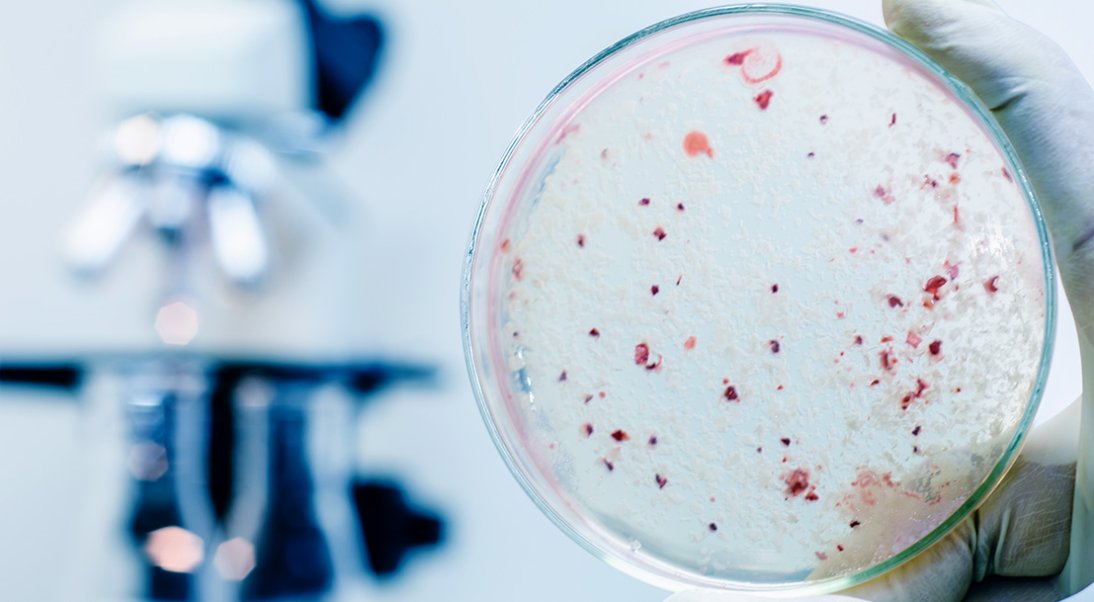
Laboratoires officiels Rage

Laboratoires officiels Rage
Ministère de l’Agriculture —

Laboratoires nationaux de référence et autres laboratoires nationaux agrées
🌍 Aujourd’hui, 0 communiqués publiés par des médias et associations du monde entier !
Des récits captivants, des biographies puissantes… disponibles dès maintenant sur Amazon.
Ministère de l’Agriculture —
Un espace ouvert aux journalistes, influenceurs, YouTubeurs, associations et créateurs pour partager vos actualités et communiqués.
📝 Publiez votre annonce gratuitementDécouvrez les dernières publications du Centre de Presse :
Voir tous les communiqués